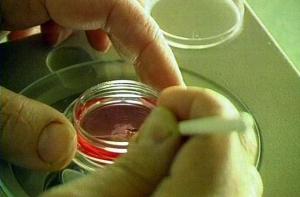
Испанские огурцы могут быть опасны для здоровья

Читайте нас также
Источником вспыхнувшей в Германии опасной кишечной инфекции, которая уже привела к первым летальным исходам, стали огурцы, импортированные из Испании, сообщает DW-WORLD со ссылкой на заключение гамбургского института гигиены.
По данным Financial Times Deutschland, эксперты института обнаружили бактерии возбудителя инфекции - высокопатогенной кишечной палочки Escherichia coli (ЭГЭК) - на четырех огурцах, три из которых были импортированы из Испании. Где был выращен четвертый огурец, пока установить не удалось.
Земельный министр здравоохранения в правительстве Гамбурга Корнелия Прюфер-Штрокс отметила, однако, что результаты анализов действительны только для Гамбурга и могут лишь ограниченно использоваться в других регионах, где могут быть иные источники кишечной инфекции.
Ранее берлинский институт имени Роберта Коха предостерег граждан от употребления в пищу овощей из северной Германии в особенности помидор, огурцов и салата. Опрос пациентов, попавших в больницу с острой кишечной инфекцией, показал, что они часто употребляли указанные продукты.

Со своей стороны представители Немецкого союза сельхозпроизводителей отмечали, что непосредственный источник заражения находится за границей. Подчеркивалось, что в северной Германии овощи еще даже не созрели, и, кроме того, при их выращивании не используется навозных удобрений, благодаря которым кишечная палочка могла бы попасть на овощи.
По словам директора института имени Роберта Коха Райнхарда Бургера , сейчас в Германии наблюдается самая мощная из до сих пор зарегистрированных вспышек кишечной инфекции, вызванная ЭГЭК. Ее отличительной особенностью является быстрота распространения и тяжелые формы протекания болезни.
К среде, 25 мая, было зафиксировано 600 подтвержденных и предположительных случаев заболевания. Наиболее тяжелая ситуация сложилась на севере Германии, прежде всего в Гамбурге и Шлезвиг-Гольштейне, где насчитывается около 400 заболевших. В целом случаи заражения были выявлены в 15 из 16 федеральных земель ФРГ.
При этом, как отмечает FTD, у 214 пациентов болезнь протекает в форме гемолитико-уремического синдрома (ГУС), для которого характерна гемморагическая диарея, острая почечная недостаточность и анемия. По некоторым данным, две третьих заболевших - женщины. Две пожилые пациентки 89-ти и 83 лет и одна молодая женщина уже скончались от последствий заражения.
_фото с сайта sadoved.com, NEWSru.com_